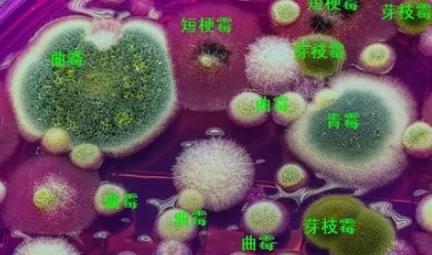

…ΫΕΪΩΐΖα…ζΈοΩΤΦΦ”–œόΙΪΥΨ
ΒΊ÷ΖΘΚ…ΫΕΪ Γ.Χ©Α≤ –.Χ©«Α
ΒγΓΓΓΓΜΑΘΚ0538-8505866
¥ΪΓΓΓΓ’φΘΚ0538-8505966
≤ΤΗΜ»»œΏΘΚ18660886576
¥σΦ“ΚΟΘ§”…”ΎΡœΟάΑΉΕ‘œΚΨΏ”–ΚήΗΏΒΡ”Σ―χΦέ÷ΒΚΆΨ≠ΦΟ–ß“φΘ§Ιψ¥σΥ°≤ζ≈σ”―Ε‘ΡœΟάΑΉΕ‘œΚΒΡΙΊΉΔ≥ΧΕ»“ά»ΜΚήΗΏΘ§±ΨœΒΝ–ΫΪΈß»ΤΕ‘œΚΝμ“ΜΗω≥ΘΦϊΦ≤≤ΓΓΣΓΣΑΉ±ψΉέΚœ’ςΘ§Ε‘ΤδΫχ––ΫœΈΣœξœΗΒΡΖ÷ΈωΘ§ΝΥΫβΓΑΑΉ±ψΓ±≤ζ…ζ‘≠“ρΘ§ΧΊΒψΚΆΖά÷Έ ÷ΕΈΓΘ
“ΜΓΔΓΑΑΉ±ψΓ±ΧΊΒψ
Ε‘œΚ≈≈≥ωΧεΆβΒΡΖύ±ψœΗ≥Λ≥ ΑΉ…ΪΘ®»γΟόœΏΘ©ΓΔ ”–’≥–‘ΓΔ≥ΘΗΓ”ΎΥ°ΟφΘ§¥σΝΩΓΔ≥ΛΤΎΨέΦ·Μα…ΔΖΔΕώ≥τΓΘ≤Γ÷Δ≥θΤΎΕ‘œΚ…ψ ≥’ΐ≥ΘΘ§Χε±μΈόΟςœ‘≤Γ±δΓΘΒΪΥφΉ≈≤Γ«ιΦ”÷ΊΘ§÷πΫΞ≥ωœ÷≥‘Νœ¬ΐ…θ÷Ν≤Μ≥‘ΝœΜρœΚ…μ ί»θΘ®Ω«»βΖ÷άκΘ©Θ§«“ΑιΥφ”ΈΧΝΚΆΓΑΆΒΥάΓ±Θ®œΚ≥ΠΒάΖΔΚλΜρ≥ΠΒά”–ΑΉ…Ϊ≈ßΉ¥ΈοΘ©ΓΘΒδ–ΆΒΡ≥ΠΒά≤Γάμ±δΜ·ΈΣ’≥ΡΛœ¬≤ψœΗΑϊ‘ω…ζΘ§…œΤΛœΗΑϊΆ―¬δΘΜ‘ω…ζ≤ΔœΥΈ§Μ·ΒΡœΗΑϊ≤ψ’ϊΧεΆ―¬δΘ§«“Ω…Εύ¥ΈΆ―¬δΘ§–Έ≥…Εύ¥ΈΑΉ±ψΓΘ

ΕΰΓΔΓΑΑΉ±ψΓ±‘≠“ρΖ÷Έω
1ΓΔœΗΨζΗ–»Ψ
œΗΨζΗ–»Ψ «Ε‘œΚΑΉ±ψ≤ΓΒΡ÷ς“Σ≤Γ“ρΘ§¥”ΜΦ≤ΓΒΡΕ‘œΚ÷–Φλ≤βΒΫ¥σΝΩΒΡΗ±»ή―ΣΜΓΨζΓΔΙΰΈ§ œΜΓΨζΓΔ¥¥…ΥΜΓΨζΓΔΜτ¬“ΜΓΨζΒ»÷¬≤ΓΨζΘ§«÷»ΨΕ‘œΚΒΡΗΈ“»‘ύ”κ≥ΠΒάΒ»ΓΘΜτ¬“ΜΓΨζ«±ΖϋΤΎ≥ΛΘ§≤Γ÷Δ«≥Θ§≤Μ“Ή≤λΨθΓΘ“ΜΒ©¬ΐΝœΜρ≤Μ≥‘Νœ“―Ψ≠ «ΚσΤΎΘ§Μυ±ΨΚήΡ―ΆλΨ»Θ§¥Υ≤ΓΚσΤΎΗΈ“»‘ύΜΒΥάΘ§≤Δ”–¥σΝΩΒΡΑΉ…Ϊ’≥“ΚΕ¬»ϊ≥ΠΒάΓΘ”…Η±»ή―ΣΜΓΨζΓΔΙΰΈ§ œΜΓΨζΓΔ¥¥…ΥΜΓΨζΒ»“ΐΤπΒΡ≥ΠΒάΗϋΚλΘ§Ά§ ±“≤ΆυΆυΑιΥφΉ≈ΜΤΆ»ΓΔΚλ–κΓΔΚλΈ≤ΓΔΚΎ»ζΒ»Θ§≥ΘΑι”–Υ°÷ ΒΡ“λ≥ΘΓΘ’κΕ‘’β÷÷«ιΩωΘ§ Ι”ΟΩΙΨζ“©ΈοΘ§‘ΌΗ®“‘―ΩφΏΗΥΨζΓΔ»ιΥαΨζάύ≤ζΤΖ Ι”ΟΘ§ΜαΒΟΒΫΫœΚΟΒΡ¥Πάμ–ßΙϊΓΘ
2ΓΔ‘εΕΨΥΊ
‘εΕΨΥΊ÷–”–“ΜάύΗΈΕΨΥΊΘ§Ϋχ»κΒΫœΚΧεΡΎΚσΘ§ΜαΒΦ÷¬ΗΈ“»‘ύ÷Ή¥σΘ§Έ°ΥθΓΔ≥ω―ΣΓΔΜΒΥά“‘ΦΑΈΗ≥ΠΒά―Ή÷ΔΓΔΜΒΥάΒ»≤Γ±δΘ§«–ΩΣΗΈ‘ύΩ…ΦϊΟςœ‘ΒΡΚΎ…ΪΓΔΜΤ…ΪΜρΚλ…ΪΒΡ“ΚΧεΝς≥ωΘ§ΕχœΚΧεΟΜ”–Οςœ‘ΒΡ≤Γ÷ΔΘ§’β÷÷«ιΩω¥Πάμ Ήœ»ΆΘΝœ3~5 ΧλΘ§»ΜΚσ Ι”Ο…ζΈο”–ΜζΥαΓΔΗ·÷≥ΥαΓΔΕύΈ§άύ≤ζΤΖΒ»ΒςΥ°ΫβΕΨΘ§ΧαΗΏΕ‘œΚΟβ“ΏΝΠΘ§«ιΩωΜαΒΟΒΫ”––ßΒΡΜΚΫβΓΘ

3ΓΔ¬ΐ–‘÷–ΕΨ
¬ΐ–‘÷–ΕΨ“ΜΑψ «”…Υ°÷ ΕώΜ·ΓΔΒΉ÷ ±δΜΒ≥ΛΤΎΒΟ≤ΜΒΫΗΡ…ΤΥυ“ΐΤπΓΘΡœΟάΑΉΕ‘œΚ «ΒΉΤή…ζΈοΘ§…ζΜν‘Ύ÷–œ¬≤ψΥ°ΧεΘ§”…”Ύ≤–ΕϋΓΔΖύ±ψΓΔΥά‘ε¥σΝΩάέΜΐ“‘ΦΑάΡ”Ο–θΡΐ–‘ΒΉΗΡΒ»“ρΥΊΒΦ÷¬ΗΟ≤ψΥ°÷ ΓΔΒΉ÷ ΖΔ»»ΓΔΖΔ≥τΓΔΖΚΥαΘ§…ζΈοΚΆΜ·―ßΚΡ―θΝΩ¥σΘ§Α±ΒΣΓΔ―«œθΥαΓΔΝρΜ·«βΓΔ‘εΕΨΥΊΒ»”–ΕΨΈο÷ ―œ÷Ί≥§±ξΓΘ≥…ΈΣΟϊΗ±Τδ ΒΒΡΓΑΨέΕΨ≤ψΓ±Θ§ΟΜ”–ΒΟΒΫΦΑ ±ΒΡœϊ≥ΐΘ§ΜαΦ”÷ΊΕ‘œΚΗΈ“»‘ύΗΚΒΘΘ§Η· ¥≥Π’≥ΡΛΒ»Θ§ΒΦ÷¬ΓΑΑΉ±ψΓ±ΓΘΟφΕ‘’β÷÷«ιΩωΘ§ Ήœ» Β±ΒΡΜΜΥ°Θ§‘Ό Ι”Ο―ΩφΏΗΥΨζΤΟ»ςΥ°ΟφΦΑ ±Ζ÷ΫβΉΣΜ·≥ΊΒΉ”–ΜζΈοΘΜ‘Ό Ι”Ο‘ω―θ–ΆΒΉΗΡΦΝ‘ωΦ”ΒΉ≤Ω»ή―θΘ§Υ°÷ ΜαΒΟΒΫΗΡ…ΤΘ§ΓΑΑΉ±ψΓ±“≤ΜαΒΟΒΫΜΚΫβΓΘ
4ΓΔΟΙΨζΕΨΥΊ
ΗΏΈ¬≥± ΣΦΨΫΎΒΡΥ«Νœ‘≠≤ΡΝœΆυΆυΖΔΟΙ―œ÷ΊΓΘ”…”ΎΝ”÷ ΒΡ‘≠ΝœΚΆ÷ϋ¥φΖΫΖ®≤ΜΒ±Β»‘≠“ρΘ§ΆυΆυ‘λ≥…Υ«Νœ÷–ΟΙΨζΕΨΥΊ≥§±ξΓΘ≥ΛΤΎ ≥”ΟΟΙ±δΒΡΥ«ΝœΘ§‘λ≥…Ε‘œΚΗΈœΗΑϊΜΒΥάΘ§ΗΈ“»‘ύΫβΕΨΚΆœϊΜ·ΙΠΡή’œΑ≠Θ§ΒΦ÷¬≥ΠΡΎπΛΡΛΚΆ―ΣœΗΑϊΒΡΜΒΥάΘ§ΟΙΨζΕΨΥΊ ΙΕ‘œΚΜζΧεΟβ“Ώ ήΒΫΩΊ÷ΤΘ§»ί“Ή”’ΖΔ¥σΙφΡΘΒΡΦ≤≤ΓΓΘ